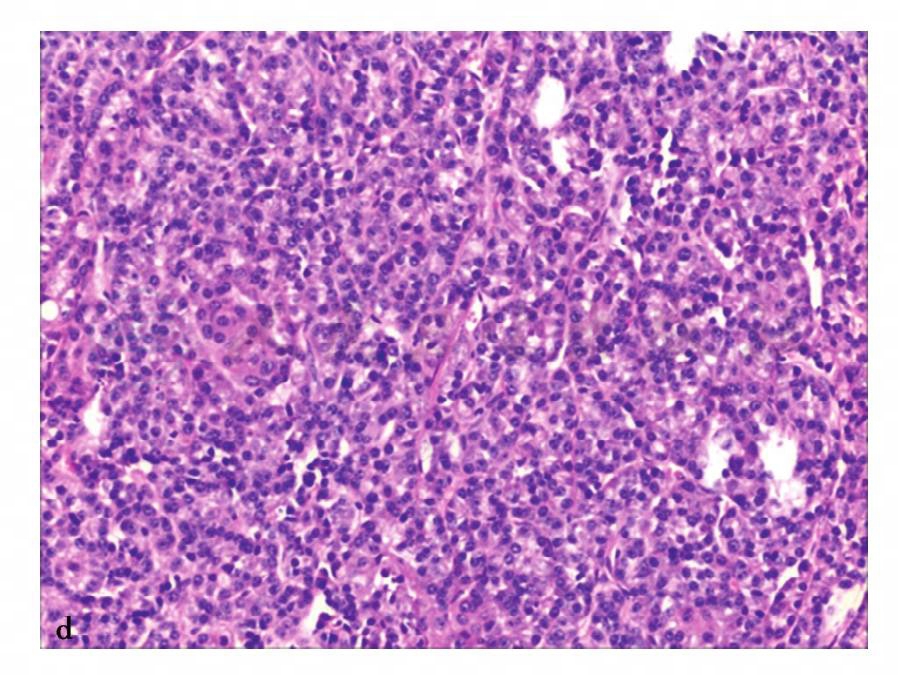

1.临床资料
病例1,男性,67岁,右乳肿块发现2年余伴疼痛3天。体格检查:双乳不对称,右乳增大,乳头后方触及约2.0cm×3.0cm肿块,质韧,边界不清,活动度差,乳头凹陷并破溃。右腋窝及锁骨上可及多个淋巴结,质硬,活动差。肿瘤标志物示:癌胚抗原(CEA)升高。
2.影像所见


图1 图a,乳腺X线头尾位(CC位)、内外斜位(MLO位)。乳腺X线示乳晕后不规则肿块,边界不清,密度增高,牵拉乳头,皮肤增厚粘连,图b,超声纵切面图。超声示不均匀低回声肿块,边界不清,呈蟹足状向周围延伸,其内及周围丰富血流。图c~f,MRI检查。图c,横断面T1加权成像,图d,横断面T2加权成像,图e,同一层增强抑脂T1加权成像横断面,图f,时间—信号强度曲线。MRI示右乳中央区不规则肿物,边界不清,T1WI、T2WI不均匀稍低信号,动态增强后呈不均匀强化,时间—信号强度曲线呈流出型,乳头内陷并强化
诊断
病例2:病理涂片

图2 g、h,病理结果为浸润性癌(见文后彩图)
诊断:病例2,浸润性癌,局部见脉管内癌栓

图3 病理证实为鼻腔NK/T细胞淋巴瘤

图4 c,心脏CT容积再现图像示冠状动脉未见明显狭窄征象

图5 a,VR重组图像,可见前降支近段近段管腔局限性变窄

图6 c,心脏VR重组图像,两者均显示:心包广泛增厚呈壳状钙化,即盔甲心,以右心缘及心膈面为主,主要累及右心房、室,右心房高度扩张,右心室舒张受限而相对较小

图7 a、c,为同一角度左冠状动脉前降支VRT重组图像

图8 b,胸腹主动脉VR重组图像见主动脉真假腔

图9 d,VR重组图像示主-肺动脉异常通道,右冠状动脉起源于升主动脉侧壁

图10 a,双下肢动脉非去骨VR重组图像

图11 d,右股浅动脉彩色超声多普勒图像示右侧股浅动脉管腔内充盈缺损大于90%,相应管腔明显变窄,仅见纤细血流显示(蓝色血流),伴随股静脉充盈良好
图12 d,病理诊断:胰腺无功能性神经内分泌肿瘤

图13 e,病理诊断:右肾透明细胞癌FurhmanⅡ级

图14 e,病理诊断:左肾慢性肉芽肿性炎伴广泛坏死,符合肾结核病变

图15 e,病理诊断:肾嗜酸细胞腺瘤

图16 i,病理诊断:右肾血管平滑肌瘤

图17 e,病理诊断:(胰头部腹膜后)神经鞘瘤

图18 c,病理示镜下所见腺体扩张拉长呈裂隙状

图19 c,病理示镜下可见导管上皮增生呈乳头状

图20 l,MRI容积重建(VR)图

图21 i,肿瘤间质细胞丰富,异型不明显,未见核分裂象

图22 h,间质呈明显的肉瘤样特征,通常表现为纤维肉瘤改变肿

图23 e,病理结果:男性乳腺发育

图24 g、h,病理结果为浸润性癌



